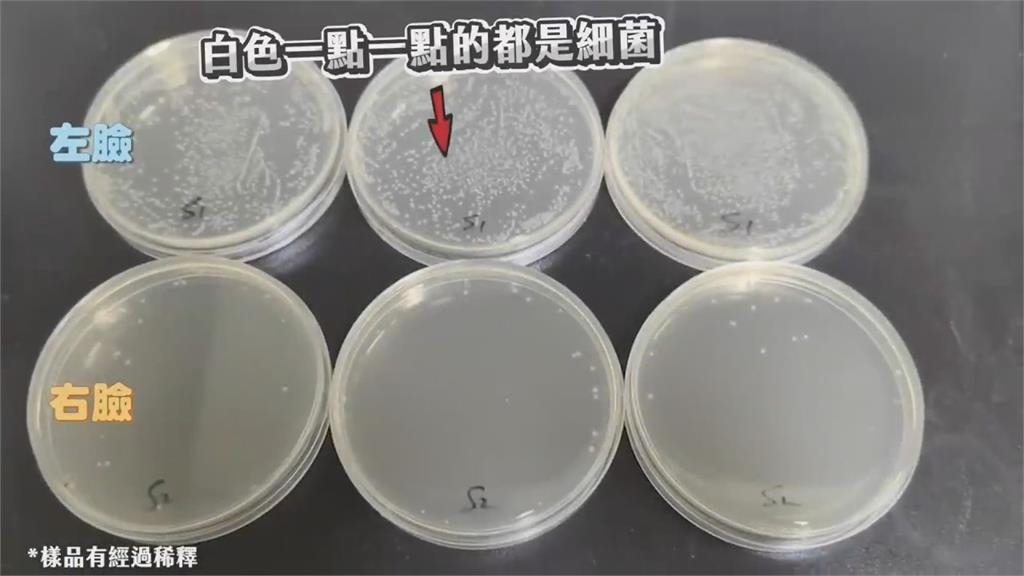

臉上不斷冒痘好困擾 1行為讓細菌暴增他勸:別再做
 2023-07-07 17:43
2023-07-07 17:43
- 小
- 中
- 大
影音中心/陳瑞婷報導「長痘痘」不是只有在青春期才會發生,而是不分男女老少都會遇到的肌膚狀況,同時也是很多人都想改善的問題。對此,喜歡在網路上分享保養心得的Ivan,之前就有提到,肌膚會長痘痘的主要原因有三類,分別為使用不適合的保養品、環境因素以及內分泌問題,但這次他發現,其實不只有這些原因,還有一個行為,導致臉上不斷冒痘,那就是用手摸臉頰。
影音中心/陳瑞婷報導
「長痘痘」不是只有在青春期才會發生,而是不分男女老少都會遇到的肌膚狀況,同時也是很多人都想改善的問題。對此,喜歡在網路上分享保養心得的Ivan,之前就有提到,肌膚會長痘痘的主要原因有三類,分別為使用不適合的保養品、環境因素以及內分泌問題,但這次他發現,其實不只有這些原因,還有一個行為,導致臉上不斷冒痘,那就是用手摸臉頰。
Ivan坦言,前一陣子自己就是因為常摸臉頰,導致臉上痘痘不斷浮現,再加上有統計發現,國人會不自覺摸臉或托腮的次數,平均每一小時就有三到五次,這讓他不禁好奇,究竟用手摸臉頰這個動作,會產生多少細菌?

於是Ivan開始紀錄,右臉是自己無意識做出摸臉或托腮的動作,而左臉則是Ivan自己有意識的去觸碰,最後再去實驗室檢驗,看看一整天下來,哪邊的摸臉次數較多,又是哪邊的細菌最多。

整天下來,Ivan發現自己無意識摸臉的次數總共有21次;有意識的摸臉則是高達47次,兩者相差約兩倍之多。進入實驗室後,Ivan就開始蒐集樣本,將左右臉所採集到的樣本放進培養皿中,來分析兩者的細菌數量。

隔天回到實驗室查看最終結果時,Ivan非常驚訝,因為左臉跟右臉的細菌數,總共相差了24倍,超乎他的想像,他也藉此呼籲,若想要讓臉頰不再長痘痘,最好戒掉用手摸臉這個壞習慣,以免細菌不斷滋生,進入長痘痘的無限循環中。
【原文出處】:臉上不斷冒痘好困擾 1行為讓細菌暴增他勸:別再做
 {PLAYICON}
{PLAYICON} {PLAYICON}
{PLAYICON} {PLAYICON}
{PLAYICON}
